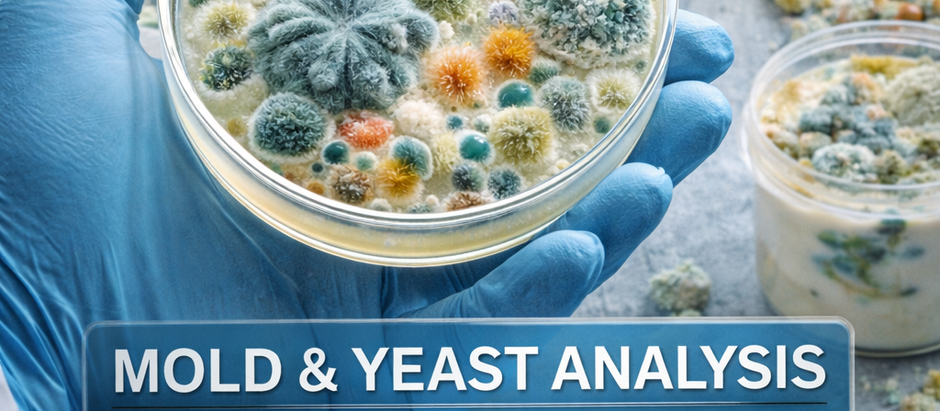
Placas de cultura com crescimento de bolores e leveduras analisadas em laboratório.

top of page
Buscar


Análises Obrigatórias em Suplementos Alimentares Segundo a ANVISA: Requisitos, Métodos e Garantia da Qualidade
A confiabilidade de um suplemento alimentar não está apenas em sua formulação, mas na robustez das análises que comprovam sua segurança, pureza e conformidade regulatória
8 de abr.5 min de leitura


Monitoramento de Agrotóxicos em Água Potável: Avaliação, Controle e Desafios Analíticos
Garantir a potabilidade da água vai além da eliminação de microrganismos: exige vigilância constante sobre contaminantes químicos invisíveis, como os agrotóxicos
8 de abr.4 min de leitura


Análise de matérias estranhas no alimento: segurança, métodos e importância para a qualidade alimentar
A segurança dos alimentos é um dos pilares fundamentais da saúde pública e da confiança do consumidor.
8 de abr.5 min de leitura


Como saber se meu whey protein é de qualidade?
O mercado de suplementos alimentares cresceu de forma impressionante nos últimos anos.
8 de abr.8 min de leitura


Lítio (Li) em Águas Naturais e Possíveis Efeitos na Saúde: Aspectos Científicos, Regulatórios e Analíticos
A presença de lítio em águas naturais, embora historicamente negligenciada, emerge como um tema estratégico na interface entre saúde pública, sustentabilidade e inovação tecnológica
8 de abr.7 min de leitura


Qualidade do Ar em Academias: Contaminação Associada à Alta Circulação de Pessoas
“Ambientes de alta performance física exigem também alta performance na qualidade do ar, pois respirar segurança é tão importante quanto treinar com intensidade
7 de abr.4 min de leitura


Por que a matéria orgânica na água merece sua atenção?
Você já abriu a torneira e sentiu um cheiro de terra ou de ovo podre? Já notou uma coloração amarelada na água de um rio próximo?
7 de abr.10 min de leitura


Análise de Cronobacter sakazakii: segurança microbiológica em alimentos infantis e controle laboratorial
A análise de Cronobacter sakazakii tem ganhado crescente relevância no cenário da segurança de alimentos, especialmente quando se trata de produtos destinados a populações vulneráveis, como recém-nascidos e lactentes.
6 de abr.5 min de leitura


Análise de Iodo: Importância do Controle em Suplementos Tireoidianos
A espectrometria de massas com plasma indutivamente acoplado (ICP-MS) permite a detecção precisa de iodo em níveis traço, sendo essencial para o controle de qualidade em suplementos tireoidianos
6 de abr.4 min de leitura


Produtos de Limpeza e Resíduos Tóxicos Invisíveis: Avaliação, Riscos e Controle Laboratorial
A limpeza eficaz não deve ser confundida com segurança química: resíduos invisíveis podem representar riscos tão relevantes quanto os contaminantes que se busca eliminar.
6 de abr.5 min de leitura


Análise de Guaraná: Controle de Cafeína Natural em Matérias-Primas e Formulações
O controle analítico da cafeína em guaraná é fundamental não apenas para padronização, mas para garantir autenticidade e segurança ao consumidor
6 de abr.5 min de leitura

Análise de Bolores e Leveduras em Alimentos e Suplementos: Indicadores de Qualidade e Segurança
Bolores e leveduras não são apenas indicadores de deterioração, mas sinais críticos de falhas no controle ambiental e riscos potenciais à segurança alimentar.
5 de abr.3 min de leitura


Análise de Lisina: Importância no Controle de Qualidade Nutricional em Suplementos e Alimentos Funcionais
O método de furosina é amplamente utilizado para estimar a lisina bloqueada por reações de Maillard, sendo um indicador importante da perda de qualidade nutricional em alimentos processados
5 de abr.5 min de leitura


Qualidade do Ar em Indústrias de Suplementos: Controle Ambiental, Riscos e Conformidade
A qualidade do ar não é apenas um requisito ambiental, mas um elemento essencial para a integridade e segurança dos suplementos alimentares
4 de abr.5 min de leitura


Legionella em Sistemas de Água: Riscos, Monitoramento e Estratégias de Controle
O controle de Legionella não deve ser reativo, mas sim preventivo, baseado em gestão de risco e monitoramento contínuo
4 de abr.6 min de leitura


Análise de Cronobacter spp.: importância, métodos e segurança alimentar
A análise de Cronobacter spp. tem se tornado um tema de crescente relevância no campo da microbiologia de alimentos, especialmente devido ao impacto desse microrganismo na saúde pública.
3 de abr.5 min de leitura


Análise de Vitamina D: controle de potência e estabilidade em suplementos
Na análise da vitamina D, precisão não é apenas uma exigência técnica, mas um requisito clínico.
3 de abr.6 min de leitura


Parâmetros Físico-Químicos Críticos na Água: Fundamentos, Monitoramento e Aplicações Institucionais
O controle dos parâmetros físico-químicos da água é essencial para garantir não apenas a conformidade regulatória, mas também a eficiência e a segurança dos sistemas que dependem desse recurso.
2 de abr.6 min de leitura


Análise de Vitamina C: Estabilidade e Degradação ao Longo do Shelf Life
A estabilidade da vitamina C não é apenas uma questão de formulação, mas um reflexo direto da integração entre ciência analítica, engenharia de processos e controle de qualidade.
2 de abr.5 min de leitura


Análise de Ômega-3: Pureza, Oxidação e Qualidade do Óleo em Contextos Científicos e Industriais
A qualidade do ômega-3 não é definida apenas por sua concentração de EPA e DHA, mas pela integridade química do óleo e ausência de compostos oxidativos e contaminantes.
2 de abr.4 min de leitura
bottom of page
